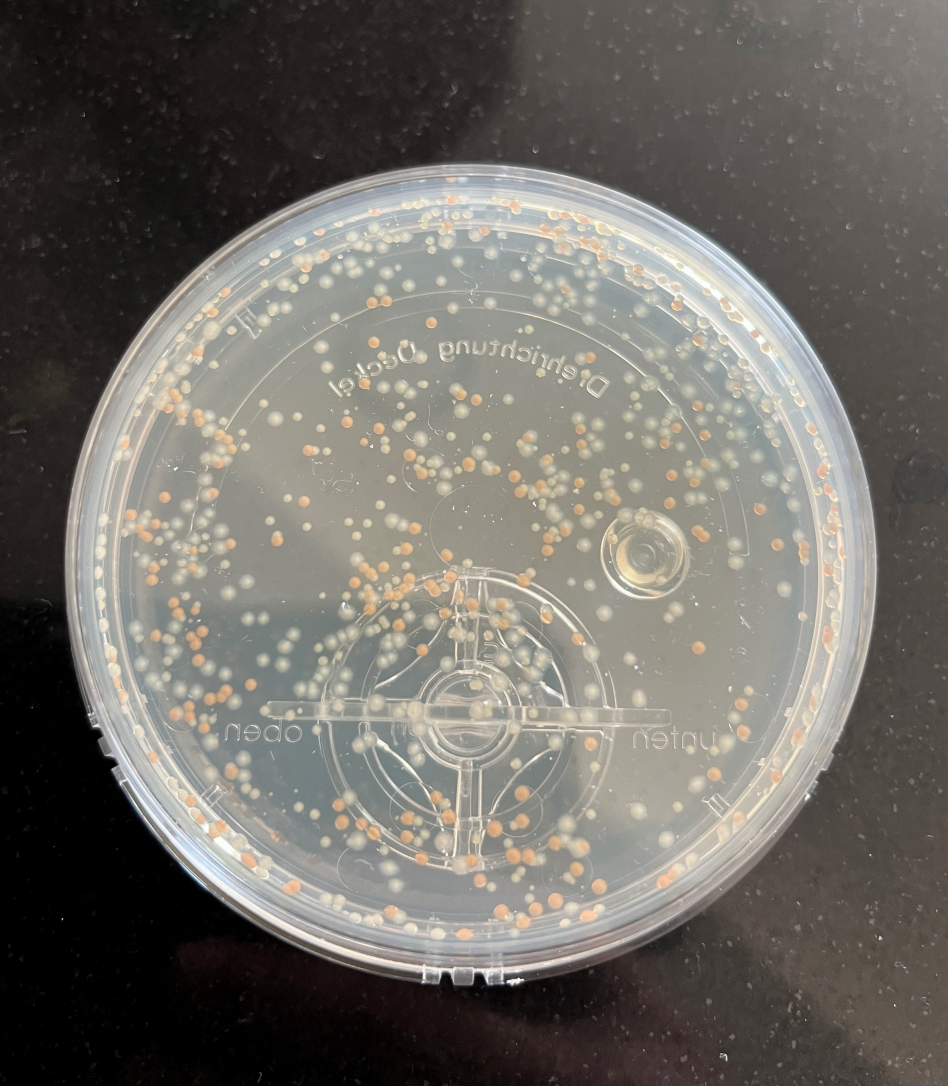
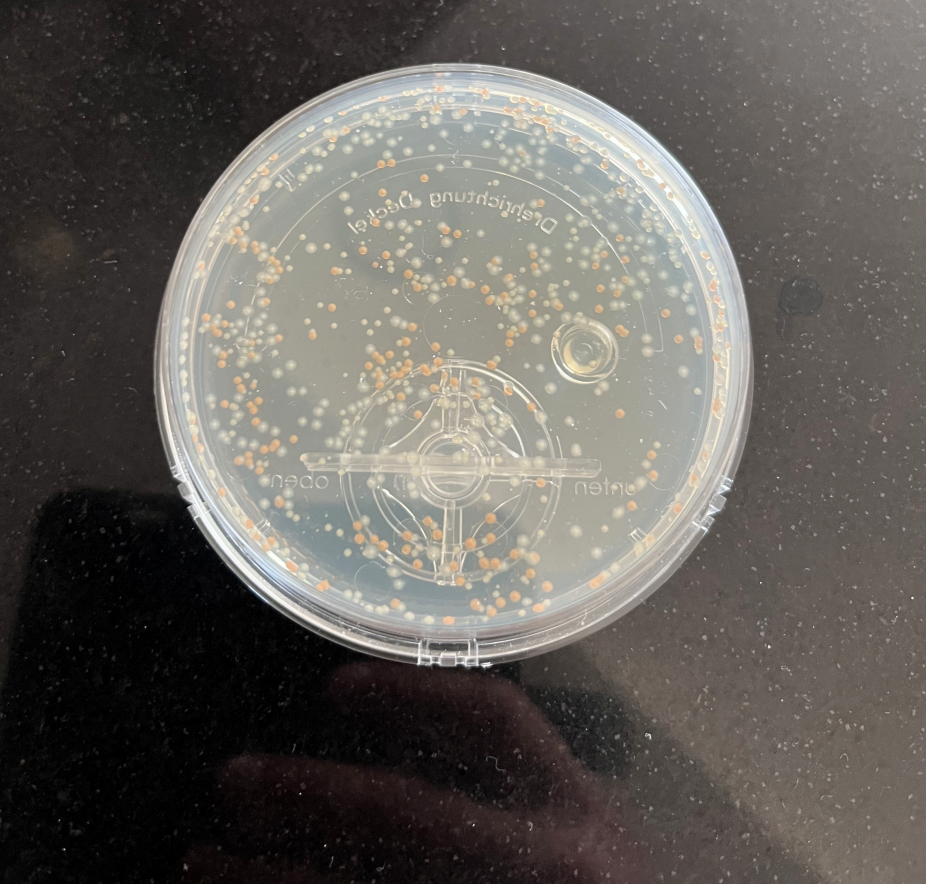

für dein Trinkwasser
Möchtest du sicherstellen, dass dein Trinkwasser frei von Bakterien und Keimen ist?
Hier biete ich einen gezielten Test nur auf mikrobiologische Verunreinigungen (Bakterien, Pilze, u.a.) auf die aerobi Gesamtkeimzahlbestimmung Wasser an.
Wichtige Information vorab:
Jeder einzelne Punkt bedeutet eine sog. kolonienbildende Einheit.
Jeder einzelne Punkt besteht aus sehr vielen einzelnen Bakterien/Pilzen (Kolonie).
Für ein gesundes Trinkwasser gilt 0 Punkte, also keine Bakterien/Pilze!

Hochwertiges Trinkwasseraufbereitungssystem (Umkehrosmose, unter Spüle)
0 Punkte- keine Bakterien/Pilze
Trinkbar und gesund
Flaschenwasser (Plastikflaschen)
zahlreiche kolonienbildende Einheiten
Nicht trinkbar!

Leitungswasser
zahlreiche kolonienbildende Einheiten
Nicht trinkbar!
Wasser aus einer handelsüblichen Osmoseanlage
zahlreiche kolonienbildende Einheiten
Nicht trinkbar!

Wasser aus einem Wasserfilter
zahlreiche kolonienbildende Einheiten
Nicht trinkbar!

Wasser aus einem Auftischanlage (Osmose)
zahlreiche kolonienbildende Einheiten
Nicht trinkbar!
Teste jetzt dein Trinkwasser
Sorge dafür, dass dein Wasser wirklich sauber und sicher ist.
Mein gezielter Wassertest prüft zuverlässig auf Bakterien, Pilze und andere mikrobiologische Verunreinigungen. Du erhältst eine detaillierte Analyse der wichtigsten chemischen und physikalischen Parameter. Und siehst genau was in deinem Wasser steckt und kannst die Qualität objektiv beurteilen.
Schütze

